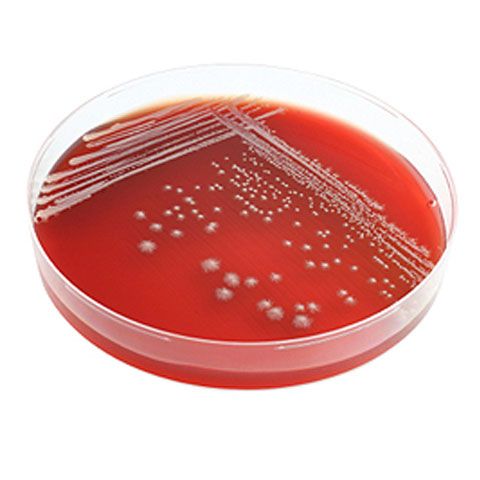
Top 10 descoperiri ştiinţifice accidentale

Top 10 descoperiri ştiinţifice accidentale
Top 10 descoperiri ştiinţifice accidentale
Louis Pasteur spunea: ''Şansa favorizează minţile pregătite''. Vorblele lui Pasteur rămân valabile şi în cazul celor zece descoperiri accidentale. Oamenii de ştiinţă care au făcut aceste descoperiri erau pregătiţi pentru ele. Ei fost capabili să vadă magia dintr-o eroare, coincidenţă, sau dintr-un obstacol. Astfel au apărut lucruri care au revoluţionat evoluţia omenirii.
10. Zaharina a fost descoperită pentru că omul de ştiinţă, Constantin Fahlberg nu s-a spălat pe mâini după ce s-a întors de la birou. În 1879, chimistul încerca să găsească noi utilităţi pentru smoala de cărbune. După o zi productivă la muncă, Fahlberg s-a întors acasă şi atunci s-a întâmplat ceva ciudat.
El a observat că rulourile pe care le mânca erau foarte dulci. Şi-a întrebat soţia dacă a adăugat un nou ingredient în mâncare, iar atunci când ea a negat, Fahlberg a realizat că gustul se datorează mâinilor sale murdare. A doua zi s-a întors în laboratorul şi a început să îşi guste ''munca'', până a descoperit punctul dulce. Astfel a apărut zaharina.
9. ''Praful inteligent''
Cei mai mulţi dintre noi am fi extrem de supăraţi dacă tema de la şcoală ne-ar exploda în faţă şi s-ar fărămiţa într-o mulţime de bucăţi. Nu este însă şi cazul studentei Jamie Link de la Universitatea din California.
În timp ce Jamie Link lucra la proiectul de doctorat în chimie, o bucată de silicon a explodat pur şi simplu. Imediat după acest moment, studenta a observat că acele mici bucăţi de silicon, rezultate din explozie funcţioneau în continuare ca senzori. Jamie Link a primit pentru ''praful inteligent'' un premiu de inventică în 2003.
Micii senzori pot fi utilizaţi pentru a monitoriza puritatea apei potabile sau a apei de mare, pentru a identifica diferite particule biologice sau chimice din aer şi chiar pentru a localiza şi a distruge tumorile din corp.
8. Cola a fost inventată accidental de farmacistul John Pemberton, în timp ce încerca să prepare un remediu pentru durerile de cap. A amestecat mai multe ingrediente, a căror identitate este păstrată secretă şi acum, şi aşa a luat naştere cea mai celebră băutură răcoritoare. Cola a fost comercializată timp de opt ani în farmacii, ca medicament, înainte de a deveni suficient de populară pentru a fi vândută în sticle.
7. Teflonul a fost descoperit de chimistul Roy Plunkett, în timp ce încerca să obţină un tip de chlorofluorocarbon, care să poată fi folosit pentru refrigerare. El credea că dacă va reuşi să determine un compus numit TFE să reacţioneze cu acidul clorhidric, va putea obţine refrigerantul dorit.
Pentru a începe experimentul, Plunkett a luat o cantitate mare de gaz TFE, l-a răcit, şi mai apoi l-a presat în canistre, pentru a putea fi astfel depozitat până când va fi gata pentru utilizare. Când a venit momentul să deschidă recipientul în care se găsea TFE, Plunkett nu a mai găsit nimic. Gazul dispăruse. A scuturat canistra, şi din recipient au căzut mai mulţi fulgi albi. Fulgii au fost mai apoi predaţi altor cercetători de la Institutul DuPont care au creat teflonul în forma în care îl ştim astăzi.
6. Cauciucul vulcanizat a fost decsoperit de Charles Goodyear în timp ce încerca să creeze un tip de cauciuc rezistent la frig şi la căldură. Într-o zi, Goodyear a vărsat din greşeală într-un cuptor un amestec de cauciuc şi sulfură. El a observat că amestecul s-a întărit puţin însă putea fi utilizat în continuare deşi stătuse la o temperatură ridicată. Cauciul vulcanizat descoperit de el este folosit acum pe scară largă de la cauciucuri pentru maşini, la încălţăminte sau la fabricarea pucului de hochei.
5. Plasticul a fost descoperit de asemenea, din greşeală, de chimistul Leo Hendrik Baekeland. El încerca să obţină o alternativă mai ieftină pentru bachelită (răşină sintetică obţinută prin tratarea formolului cu fenol, utilizată ca materie plastică pentru confecţionarea unor obiecte tehnice sau de uz casnic). În timpul experimentelor sale, Baekeland a obţinut accidental un amestec maleabil care putea rezista la temperaturi ridicate fără a se distorsiona. De atunci, plasticul este utilizat pe scară largă.
4. Radioactivitatea este opera fizicianului Henri Becquerel. În 1896, fascinat fiind de fluorescenţa naturală şi de razele X, el a încercat să vadă dacă minelale naturale fluorescente pot produce raze X dacă sunt lăsate mai mult timp în lumina soarelui.
Becquerel realiza aceste experimente timp de iarnă. După mai multe zile cu cer înnorat, el a renunţat temporar la experimente. A pus întreg ehipamentul împachetat într-un sertar şi a aşteptat o zi însorită. Când această zi a a venit şi s-a întors la muncă, Becquerel a observat că piatra de uraniu pe care o lăsase în sertar se imprimase pe placa fotografică chiar dacă nu fusese expusă luminii solare.
Atunci a realizat că acea piatră avea ceva special. În timp ce lucra cu Pierre şi Marie Curie, a descoperit că ceea ce era special la acea piatră era radioactivitatea.
3. Culoarea mov a fost descoperită de un tânăr chimist de 18 ani. William Perkin intenţiona de fapt să găsească un remediu pentru malarie. În 1856 Perkin lucra la crearea chininei artificiale. În urma experimentelor, el nu a obţinut însă decât o mizerie groasă şi întunecată. Cu cât se uita mai mult la această mizerie, cu atât Perkin vedea mai degrabă o culoare frumoasă, decât un simplu gunoi. În acest mod, Perkin a creat prima vopsea sintetică. Mai târziu, bacteriologul german Paul Ehrlich, inspirat de munca lui Perkin, a găsit o nouă utilitate pentru vopsea, în chimioterapie şi imunologie.
2. Stimulatorul cardiac (pacemaker) a fost descoperit pentru că inginerul american Wilson Greatbatch a introdus mâna într-o cutie şi a scos ceea ce nu trebuia. Inginerul lucra la crearea unui circuit care să ajute la înregistratea bătăilor mai rapide ale inimii. El a introdus mâna într-o cutie pentru a lua un rezistor cu care să finalizeze circuitul, însă a scos din greşeală un rezistor de 1 megaohm, în locul unuia de 10.000 ohm. Atunci circuitul a început să pulseze timp de 1,8 milisecunde după care se oprea timp de o secundă. Acest ritm se repeta în mod regulat. Sunetul era de fapt o reproducere identică a bătăilor inimii.
1.
Penicilina
a apărut în 1928 în timp ce inventatorul său se afla în vacanţă. Bacteriologul scoţian Alexander Fleming a uitat să îşi cureţe instalaţia de lucru înainte de a pleca în vacanţă. Când s-a întors a observat o ciupercă ciudată pe câteva dintre culturile sale de bacterii. Mai mult, Fleming a observat că bacteriile pe care se afla acea ciupercă nu se mai dezvoltau. Penicilina este şi astăzi unul dintre cele mai utilizate antibiotice la nivel mondial.
Citește și:
- 14:24 - O nouă ipoteză despre misterul Triunghiului Bermudelor. Ce spun cercetătorii
- 13:47 - Jeleu de căpșuni la borcan. Rețeta perfectă pentru un desert aromat și o glazură delicioasă
- 13:13 - Remedii naturale pentru amețeală. Soluții simple care pot ajuta la reducerea simptomelor
- 12:36 - Fructul consumat de milioane de oameni care poate contribui la reducerea colesterolului. Ce spun specialiștii despre beneficiile sale
Mai multe articole despre
Urmărește știrile Realitatea.NET și pe Google News














